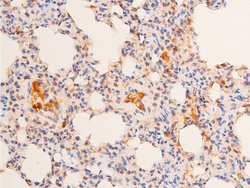
Invitrogen Phospho-p53 (Ser15) Polyclonal Antibody 100 &mu;L; Unconjugated:Antibodies,

missing translation for 'onlineSavingsMsg'
Learn More
Learn More
Invitrogen™ Phospho-p53 (Ser15) Polyclonal Antibody


Rabbit Polyclonal Antibody
Brand: Invitrogen™ PA5104742
This item is not returnable.
View return policy
Description
Antibody detects endogenous levels of p53 only when phosphorylated at Serine 15.
The tumor suppressor protein, p53, is a sequence specific transcription factor that is activated by cellular stress. p53 mediates cell cycle arrest or apoptosis in response to DNA damage or starvation for pyrimidine nucleotides. p53 is up-regulated in response to stress signals and stimulated to activate transcription of specific genes, resulting in expression of p21waf1 and other proteins involved in G1 or G2/M arrest. The structure of p53 comprises an N-terminal transactivation domain, a central DNA-binding domain, an oligomerisation domain, and a C-terminal regulatory domain. There are various phosphorylation sites on p53, of which the phosphorylation at Ser15 is important for p53 activation and stabilization. p53 has been characterized to play a role in blocking the proliferative action of damaged cells and act as an anticancer agent. Phosphorylation of Ser392 in p53 has been shown to associate with the formation of human tumors. In addition, p53 has also been linked to the effects of aging and oxidative stress and an increase in p53 has been linked to deficits in LTP (Long Term Potentiation) in learning and memory. p53 is found in very low levels in normal cells, however, in a variety of transformed cell lines, it is expressed in high amounts, and believed to contribute to transformation and malignancy. Mutants of p53 that frequently occur in a number of different human cancers fail to bind the consensus DNA binding site, and cause the loss of tumor suppressor activity. Alterations of the TP53 gene occur not only as somatic mutations in human malignancies, but also as germline mutations in some cancer-prone families such as Li-Fraumeni syndrome.
Specifications
| Phospho-p53 (Ser15) | |
| Polyclonal | |
| Unconjugated | |
| Tp53 | |
| Antigen NY-CO-13; bbl; BCC7; bfy; bhy; cellular tumor antigen p53; Cys 51 Stop; EGK_08142; FLJ92943; HGNC11998; I79_002739; LFS1; Li-Fraumeni syndrome; mutant p53; mutant tumor protein 53; OTTMUSP00000006194; p44; p53; p53 cellular tumor antigen; p53 protein; p53 tumor suppressor; p53 tumor suppressor phosphoprotein; phosphoprotein p53; Tp53; tp53.L; transformation related protein 53; transformation-related protein 53; Trp248; Trp53; tumor protein 53; tumor protein p53; tumor protein p53 (Li-Fraumeni syndrome); tumor protein p53 L homeolog; tumor suppressor p53; tumor suppressor p53 phosphoprotein; tumor suppressor protein p53; tumor supressor p53; Tumour Protein p53; XELAEV_180196761mg; Xp53; Xrel3 | |
| Rabbit | |
| sequential chromatography | |
| RUO | |
| 22059, 24842, 7157 | |
| -20°C | |
| Liquid |
| Immunohistochemistry (Paraffin), Immunoprecipitation, Western Blot, Immunocytochemistry | |
| 1 mg/mL | |
| PBS with 50% glycerol and 0.02% sodium azide; pH 7.4 | |
| P02340, P04637, P10361 | |
| Tp53, Trp53 | |
| A synthesized peptide derived from human TP53(Accession P04637), corresponding to amino acid residues around phosphorylated Ser15. | |
| 100 μL | |
| Primary | |
| Human, Mouse, Rat | |
| Antibody | |
| IgG |
Product Content Correction
Your input is important to us. Please complete this form to provide feedback related to the content on this product.
Product Title
Spot an opportunity for improvement?Share a Content Correction